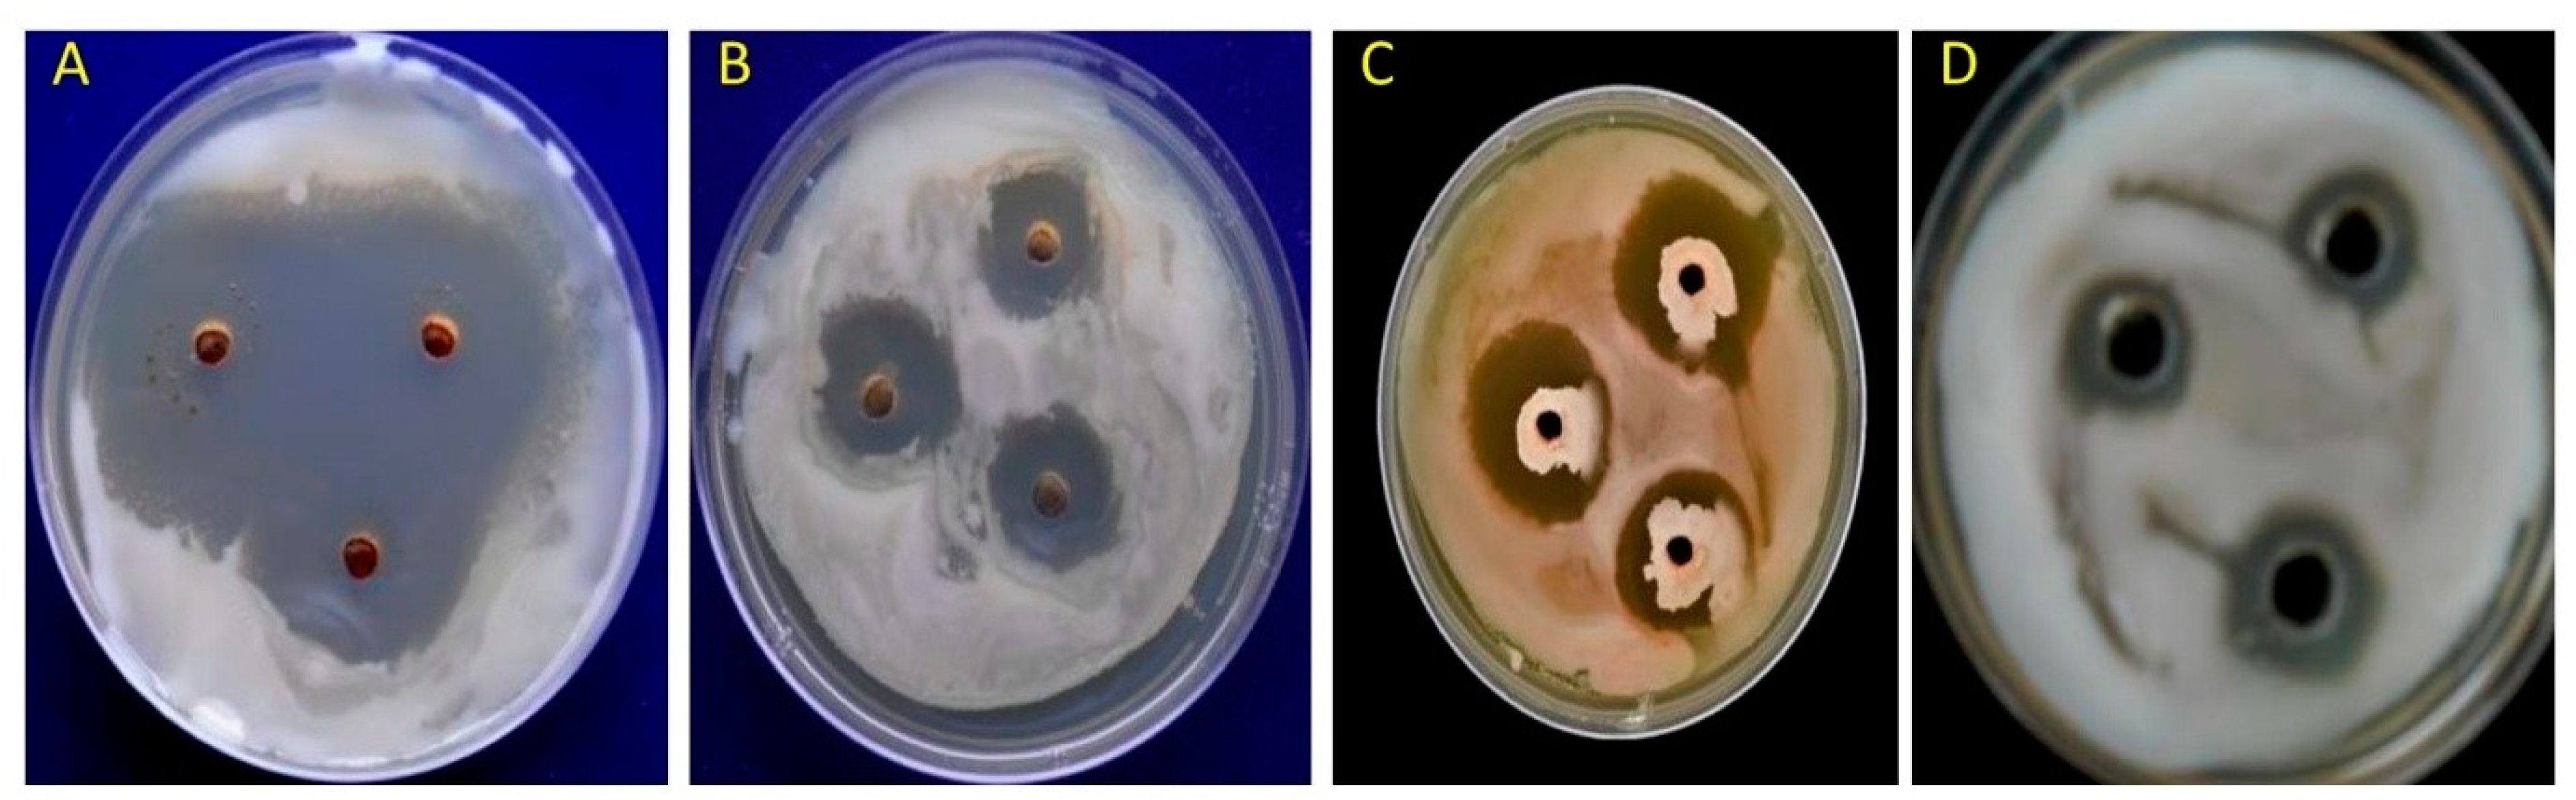

Suppression of Tomato Bacterial Wilt Incited by Ralstonia pseudosolanacearum Using Polyketide Antibiotic-Producing Bacillus spp. Isolated from Rhizospheric Soil
Abstract
1. Introduction
2. Materials and Methods
2.1. Collection of Soil Sample and Bacterial Culture
2.2. Antagonistic Ability of Bacillus spp. against R. pseudosolanacearum under In Vitro Conditions
2.3. DNA Isolation from Bacteria
2.4. Primer Designing
2.5. Standardization of Protocol for Multiplex-PCR
2.6. Screening of Polyketides Antibiotics Producing Strains of Bacillus spp.
2.7. Detection of Polyketides Antibiotics Producing Strains from Soil
2.8. Molecular Characteization of Polyketides Genes in B. amyloliquefaciens DSBA-11
2.9. Bio-Efficacy of Cloned Product under In Vitro Conditions
2.10. Bacterial Viability Test
2.11. Mechanisms of Suppression of Bacterial Wilt Disease of Tomato
2.11.1. Purification of Cloned Product of Polyketides Antibiotic Synthase Gene
2.11.2. TEM Studies
2.11.3. Statistical Analysis
3. Results
3.1. In Vitro Studyon Antagonistic Ability of Bacillus spp. against R. pseudosolanacearum
3.2. Primer Specificity and Sensitivity
3.3. Screening of Polyketides Antibiotics Producing Strains of Bacillus spp. through Multiplex PCR
3.4. Detection of Polyketides Gene from Soil DNA
3.5. Bio-Efficacy of Cloned Product of Polyketides Antibiotics Producing Gene under In Vitro Conditions
3.6. Morphological and Ultrastructural Changes of R. pseudosolanacearum Cells in the Presence of Polyketide Antibiotics
3.7. Effect of Polyketide Antibiotic-Producing B. amyloliquefaciens for Control of Bacterial Wilt
3.8. Effect of Macrolactin, Difficidin and Bacilysin on Viability of R. pseudosolanacearum Cells
4. Discussion
5. Conclusions
Author Contributions
Funding
Acknowledgments
Conflicts of Interest
References
- Yabuuchi, E.; Kosako, Y.; Yano, I.; Hotta, I.; Nishiucliy, Y. Transfer of two Burkholderia and an Alcaligenes species to Ralstonia General Nov: Proposal of Ralstoniapikettii (Ralston, Palleroni and Doudoroff 1973) Comb. Nov, Ralstonia solanacearum (Smith1896) Comb. Nov. Microbiol. Immunol. 1995, 39, 897–904. [Google Scholar] [CrossRef] [PubMed]
- Devi, R.L.; Menon, M.R. Seasonal incidence of bacterial wilt of tomato. Indian J. Microbiol. 1980, 20, 13–15. [Google Scholar]
- Singh, D.; Sinha, S.; Yadav, D.K.; Sharma, J.P.; Srivastava, D.K. Characterization of biovar/races of Ralstonia solanacearum, the incitant of bacterial wilt in solanaceous crops. Indian Phytopath 2010, 63, 261–265. [Google Scholar]
- Myint, L.; Ranamukhaarachchi, S.L. Development of biological control of Ralstonia solanacearum through antagonistic microbial populations. Inter. J. Agric. Biol. 2006, 8, 657–660. [Google Scholar]
- Chen, X.H.; Koumoutsi, A.; Scholz, R.; Borriss, R. More than anticipated-production of antibiotics and other secondary metabolites by Bacillus amyloliquefaciens FZB42. J. Mol. Microbiol. Biotechnol. 2009, 16, 14–24. [Google Scholar] [CrossRef] [PubMed]
- Singh, D.; Yadav, D.K.; Shweta, S.; Mondal, K.K.; Singh, G.; Pandey, R.R.; Singh, R. Genetic diversity of iturin producing strains of Bacillus species antagonistic to Ralstonia solanacearum causing bacterial wilt disease in tomato. Afr. J. Microbiol. Res. 2013, 7, 5459–5470. [Google Scholar]
- Singh, D.; Yadav, D.K.; Chaudhary, G.; Rana, V.S.; Sharma, R.K. Potential of Bacillus amyloliquefaciens for biocontrol of bacterial wilt of tomato incited by Ralstoniapseudosolanacearum. J. Plant Pathol. Microbiol. 2016, 7, 327. [Google Scholar] [CrossRef]
- Nguyen, M.T.; Ranamukhaarachchi, S.L. Soil-borne antagonists for biological control of bacterial wilt disease caused by Ralstonia solanacearum in tomato and pepper. J. Plant Pathol. 2010, 92, 395–406. [Google Scholar]
- Nguyen, M.T.; Ranamukhaarachch, S.L.; Hannaway, D.B. Efficacy of antagonist strains of Bacillus megaterium, Enterobacter cloacae, Pichia guilliermondii and Candida ethanolica against bacterial wilt disease of tomato. J. Phytol. 2011, 3, 1–10. [Google Scholar]
- Tan, S.; Jiang, Y.; Song, S.; Huang, J.; Ling, N.; Xu, Y.; Shen, Q. Two Bacillus amyloliquefaciens strains isolated using the competitive tomato root enrichment method and their effects on suppressing Ralstonia solanacearum and promoting tomato plant growth. Crop Prot. 2013, 43, 134–140. [Google Scholar] [CrossRef]
- Haas, D.; Geneviève, D. Biological control of soil-borne pathogens by fluorescent pseudomonads. Nat. Rev. Microbiol. 2005, 4, 307–319. [Google Scholar] [CrossRef]
- Nihorimbere, V.; Ongena, M.; Cawoy, H.; Brostaux, Y.; Kakana, P.; Jourdan, E.; Thonart, P. Beneficial effects of Bacillus subtilis on field-grown tomato in Burundi: Reduction of local Fusarium disease and growth promotion. Afr. J. Microbiol. Res. 2010, 4, 1135–1142. [Google Scholar]
- Zhang, R.S.; Liu, Y.F.; Luo, C.P.; Wang, X.Y.; Liu, Y.Z.; Qiao, J.Q.; Yu, J.J.; Chen, Z.Y. Bacillus amyloliquefaciens lX-11, a potential biocontrol agent against rice bacterial leaf streak. J. Plant Pathol. 2012, 94, 609–619. [Google Scholar]
- Chowdhury, S.P.; Dietel, K.; Rändler, M.; Schmid, M.; Junge, H.; Borriss, R.; Hartmann, A.; Grosch, R. Effects of Bacillus amyloliquefaciens FZB42 on lettuce growth and health under pathogen pressure and its impact on the rhizosphere bacterial community. PLoS ONE 2013, 8, e68818. [Google Scholar] [CrossRef]
- Rea, M.C.; Sit, C.S.; Clayton, E.; O’Connor, P.M.; Whittal, R.M.; Zheng, J.; Vederas, J.C.; Ross, R.P.; Hill, C. Thuricin CD, a post translationally modified bacteriocin with a narrow spectrum of activity against Clostridium difficile. Proc. Natl. Acd. Sci. USA 2010, 107, 9352–9357. [Google Scholar] [CrossRef]
- Stein, T. Bacillus subtilis antibiotics: Structures, syntheses and specific functions. Mol. Microbiol. 2005, 56, 845–857. [Google Scholar] [CrossRef]
- Ramarathnam, R.; Bo, S.; Chen, Y.; Fernando, W.D.; Xuewen, G.; De Kievit, T. Molecular and biochemical detection of fengycin and bacillomycin D producing Bacillus spp., antagonistic to fungal pathogens of canola and wheat. Can. J. Microbiol. 2007, 53, 901–911. [Google Scholar] [CrossRef]
- Arguelles-Arias, A.; Ongena, M.; Halimi, B.; Lara, Y.; Brans, A.; Joris, B.; Fickers, P. Bacillus amyloliquefaciens GA1 as a source of potent antibiotics and other secondary metabolites for biocontrol of plant pathogens. Microbial. Cell Factories 2009, 8, 63–74. [Google Scholar] [CrossRef]
- Chen, X.H.; Scholz, R.; Borriss, M.; Junge, H.; Mögel, G.; Kunz, S.; Borriss, R. Difficidin and bacilysin produced by plant-associated Bacillus amyloliquefaciens Dare efficient in controlling fire blight disease. J. Biotechnol. 2009, 140, 38–44. [Google Scholar] [CrossRef]
- Tamehiro, N.; Okamoto-Hosoya, Y.; Okamoto, S.; Ubukata, M.; Hamada, M.; Hiroshi, N.; Ochi, K. Bacilysocin, a novel phospholipid antibiotic produced by Bacillus subtilis 168. Antimicrob. Agents Chemother. 2002, 46, 315–320. [Google Scholar] [CrossRef]
- Inaoka, T.; Ochi, K. Glucose uptake pathway-specific regulation of synthesis of neotrehalosadiamine, a novel auto inducer produced in Bacillus subtilis. J. Bacteriol. 2007, 189, 65–75. [Google Scholar] [CrossRef] [PubMed][Green Version]
- Pinchuk, I.V.; Bressollier, P.; Sorokulova, I.B.; Verneuil, B.; Urdaci, M.C. Amicoumacin antibiotic production and genetic diversity of Bacillus subtilis strains isolated from different habitats. Res. Microbiol. 2002, 153, 269–276. [Google Scholar] [CrossRef] [PubMed]
- Wilson, K.; Flor, J.E.; Schwartz, R.E.; Joshua, H.; Smith, J.L.; Pelak, B.A.; Liesch, J.M.; Hensens, O.D. Difficidin and oxydifficidin: Novel broad spectrum antibacterial antibiotics produced by Bacillus subtilis. II. Isolation and physico-chemical characterization. J. Antibiot. 1987, 40, 1682–1691. [Google Scholar]
- Chen, X.H.; Vater, J.; Piel, J.; Franke, P.; Scholz, R.; Schneider, K.; Koumoutsi, A.; Hitzeroth, G.; Grammel, N.; Strittmatter, A.W.; et al. Structural and functional characterization of three polyketide synthase gene clusters in Bacillus amyloliquefaciens FZB42. J. Bact. 2006, 188, 4024–4036. [Google Scholar] [CrossRef] [PubMed]
- Gustafson, K.; Roman, M.; Fenical, W. The macrolactins, a novel class of antiviral and cytotoxic macrolides from a deep-sea marine bacterium. J. Am. Chem. Soc. 1989, 111, 7519–7524. [Google Scholar] [CrossRef]
- Hofemeister, J.; Conrad, B.; Adler, B.; Hofemeister, B.; Feesche, J.; Kucheryava, N.; Steinborn, G.; Franke, P.; Grammel, N.; Zwintscher, A.; et al. Genetic analysis of the biosynthesis of non-ribosomal peptide- and polyketide-like antibiotics, iron uptake and biofilm formation by Bacillus subtilis A1/3. Mol. Genet. Genom. 2004, 272, 363–378. [Google Scholar] [CrossRef]
- Jaruchoktaweechai, C.; Suwanborirux, K.; Tanasupawatt, S.; Kittakoop, P.; Menasveta, P. New macrolactins from a marine Bacillus sp. Sc026. J. Nat. Prod. 2000, 63, 984–986. [Google Scholar] [CrossRef]
- Koumoutsi, A.; Chen, X.H.; Henne, A.; Liesegang, H.; Hitzeroth, G.; Franke, P.; Vater, J.; Borriss, R. Structural and functional characterization of gene clusters directing nonribosomal synthesis of bioactive cyclic lipopeptides in Bacillus amyloliquefaciensstrain FZB42. J. Bacteriol. 2004, 186, 1084–1096. [Google Scholar] [CrossRef]
- Murry, M.G.; Thompson, W.F. Rapid isolation of high molecular weight DNA. Nucleic Acids Res. 1980, 8, 4321–4325. [Google Scholar] [CrossRef]
- Sambrook, J.; Fritsch, E.R.; Maniatis, T. Molecular Cloning: A Laboratory Manual, 2nd ed.; Cold Spring Harbor Laboratory Press: Cold Spring Harbor, NY, USA, 1989. [Google Scholar]
- Schaad, N.W.; Jones, J.B.; Chun, W. Laboratory Guide for the Identification of Plant Pathogenic Bacteria, 3rd ed.; American Phytopathological Society: St Paul, MN, USA, 2001; p. 373. [Google Scholar]
- Guo, J.H.; Qi, H.Y.; Guo, Y.H.; Ge, H.L.; Gong, L.Y.; Zhang, L.X.; Sun, P.H. Biocontrol of tomato wilt by plant growth promoting rhizobacteria. Biol. Control 2004, 29, 66–72. [Google Scholar] [CrossRef]
- Lisboa, M.P.; Bonatto, D.; Bizani, D.; Henriques, J.A.; Brandelli, A. Characterization of a bacteriocin-like substance produced by Bacillus amyloliquefaciens isolated from the Brazilian Atlantic forest. Int. Microbiol. 2006, 9, 111–118. [Google Scholar]
- Butcher, R.A.; Schroeder, F.C.; Fischbach, M.A.; Straight, P.D.; Kolter, R.; Walsh, C.T.; Clardy, J. The identification of bacillaene, the product of the pks X megacomplex in Bacillus subtilis. Proc. Natl. Acad. Sci. USA 2007, 104, 1506–1509. [Google Scholar] [CrossRef]
- Chen, X.H.; Koumoutsi, A.; Scholz, R.; Eisenreich, A.; Schneider, K.; Heinemeyer, I.; Morgenstern, B.; Voss, B.; Hess, W.R.; Reva, O.; et al. Comparative analysis of the complete genome sequence of the plant growth-promoting bacterium Bacillus amyloliquefaciens FZB42. Nat. Biotechnol. 2007, 25, 1007–1014. [Google Scholar] [CrossRef]
- Wu, L.; Wu, H.; Chen, L.; Yu, X.; Borriss, R.; Gao, X. Difficidin and bacilysin from Bacillus amyloliquefaciens FZB42 have antibacterial activity against Xanthomonas oryzae rice pathogens. Sci. Rep. 2015, 5, 12975. [Google Scholar] [CrossRef]
- Zweerink, M.; Edison, A. Difficidin and oxydifficidin: Novel broad spectrum antibacterial antibiotics produced by Bacillus subtilis. III. Mode of action of difficidin. J. Antibiotic 1987, 40, 1692–1697. [Google Scholar] [CrossRef]
- FazleRabbee, M.; Baek, K.H. Antimicrobial activities of lipopeptides and polyketides of Bacillus velezensis for agricultural applications. Molecules 2020, 25, 4973. [Google Scholar] [CrossRef]

| Primer. | Sequence (5′-3′) | Target Gene | Annealing Temp | Product Size |
|---|---|---|---|---|
| Mln-F Mln-R | CGGTGATCATGAGCGCTTTG TCGGTCTGCTTTCTCAACCC | Macrolactin | 50 °C | 792 bp |
| Dfn-F Dfn-R | GGAAATGCCTTTAATGACC GGAGCTGAATCAATTGAAGC | Difficidin | 50 °C | 705 bp |
| Bae-F Bae-R | GTCTTACCTCGATTGCTGTG CATAGGTCACGATATCCACC | Bacillaene | 52 °C | 616 bp |
| Soil Sample | Place | No of Soil Samples Tested | All Three Genes | Polyketides Genes | ||
|---|---|---|---|---|---|---|
| Bae + Dfn | Dfn + Mln | Mln + Bae | ||||
| 1 | Jharkhand | 16 | 62.5 (10) | 37.5 (6) | 0.0 | 0.0 |
| 2 | Odisha | 12 | 58.3 (7) | 16.0 (2) | 8.4 (1) | 16.8 (2) |
| 3 | West Bengal | 15 | 73.3 (11) | 0.0 | 13.3 (2) | 13.3 (2) |
| 4 | Jammu & Kashmir | 7 | 66.7 (4) | 16.7 (1) | 16.7 (1) | 16.7 (1) |
| 5 | Meghalaya | 5 | 60.0 (3) | 0.0 | 20.0 (1) | 20.0 (1) |
| 6 | Uttarakhand | 20 | 70.0 (14) | 5.0 (1) | 10.0 (2) | 15.0 (3) |
| 7 | B. amyloliquefaciens DSBA-11 and DSBA-12 (positive) | − | + | 0.0 | 0.0 | 0.0 |
| Total | 75 | |||||
| Polyketides Producing Strain of Bacillus spp. | No of Isolates Tested | Host | Place | Polyketides Genes | ||
|---|---|---|---|---|---|---|
| Bae | Dfn | Mln | ||||
| B. amyloliquefaciens | KCBA-1, KCBA-2 | Chilli rhizosphere | Karnataka | + | + | + |
| JHBA-1, JHBA-2 | Brinjal rhizosphere | Jharkhand | + | + | + | |
| MPBA-1, MPBA-2 | Potato rhizosphere | Meghalaya | + | + | + | |
| UKTBA-1, UKTBA-2, UKTBA-3 | Tomato rhizosphere | Uttarakhand | + | + | + | |
| DSBA-11, DSBA-12 | Delhi | + | + | + | ||
| B. subtilis | UTTBS-1, UTTBS-2 UTTBS-3, DTBS-4, DTBS-5 | Tomato rhizosphere | Uttarakhand & Delhi | − | + | + |
| B. subtilis | MTCC 7258 | − | MTCC Chandigarh | − | + | + |
| B. cereus | JHTBS-7 | Brinjal rhizosphere | Jharkhand | − | − | − |
| B. pumilus | MTCC-7092 | − | MTCC Chandigarh | − | − | − |
| B. licheniformis | − | Bacteriology, Div. of plant pathology | − | − | − | |
| Treatments | Inhibition Zone (Area in cm2) | Wilt Disease Intensity (%) | Biocontrol Efficacy (%) |
|---|---|---|---|
| B. amyloliquefaciens DSBA-11 (Parent) | 3.3 a | 29.3 f | 57.72 |
| Cloned product ofbacillaene (bae) | 1.9 c | 50.7 c | 26.83 |
| Cloned product ofmacrolactin (mln) | 1.9 c | 46 d | 33.62 |
| Cloned product of difficidin (dfn) | 1.7 c | 39.3 e | 43.23 |
| R. solanacearum UTT-25 | 0.0 b | 69.3 a | - |
| Non-clonedproduct | 0.0 b | 66.7 b | - |
| Treatment | Concentration (µg/mL) | Growth of R. pseudosolanacearum OD Value at 600 nm | |||
|---|---|---|---|---|---|
| 24 h | 48 h | 72 h | 96 h | ||
| Macrolactin | 10 µg/mL | 0.168 bc | 0.197 c | 0.244 c | 0.250 c |
| 50 µg/mL | 0.075 cd | 0.077 d | 0.093 gh | 0.095 f | |
| Difficidin | 10 µg/mL | 0.190 b | 0.275 b | 0.334 b | 0.339 b |
| 50 µg/mL | 0.071 cd | 0.082 d | 0.110 ef | 0.116 ef | |
| Bacillaene | 10 µg/mL | 0.181 b | 0.247 b | 0.252 c | 0.255 c |
| 50 µg/mL | 0.077 cd | 0.088 d | 0.133 e | 0.136 e | |
| Macrolactin + Difficidin + Bacillaene | 10 µg/mL | 0.074 cd | 0.086 d | 0.090 gh | 0.094 f |
| 50 µg/mL | 0.063 d | 0.070 d | 0.076 g | 0.079 f | |
| B. amyloliquefaciens DSBA-11 | 10 µg/mL | 0.128 bcd | 0.170 c | 0.190 d | 0.195 d |
| 50 µg/mL | 0.071 cd | 0.080 d | 0.102 gh | 0.107 ef | |
| Control | 1.76 a | 2.603 a | 2.88 a | 2.98 a | |
Publisher’s Note: MDPI stays neutral with regard to jurisdictional claims in published maps and institutional affiliations. |
© 2022 by the authors. Licensee MDPI, Basel, Switzerland. This article is an open access article distributed under the terms and conditions of the Creative Commons Attribution (CC BY) license (https://creativecommons.org/licenses/by/4.0/).
Share and Cite
Singh, D.; Devappa, V.; Yadav, D.K. Suppression of Tomato Bacterial Wilt Incited by Ralstonia pseudosolanacearum Using Polyketide Antibiotic-Producing Bacillus spp. Isolated from Rhizospheric Soil. Agriculture 2022, 12, 2009. https://doi.org/10.3390/agriculture12122009
Singh D, Devappa V, Yadav DK. Suppression of Tomato Bacterial Wilt Incited by Ralstonia pseudosolanacearum Using Polyketide Antibiotic-Producing Bacillus spp. Isolated from Rhizospheric Soil. Agriculture. 2022; 12(12):2009. https://doi.org/10.3390/agriculture12122009
Chicago/Turabian StyleSingh, Dinesh, Venkatappa Devappa, and Dhananjay Kumar Yadav. 2022. "Suppression of Tomato Bacterial Wilt Incited by Ralstonia pseudosolanacearum Using Polyketide Antibiotic-Producing Bacillus spp. Isolated from Rhizospheric Soil" Agriculture 12, no. 12: 2009. https://doi.org/10.3390/agriculture12122009
APA StyleSingh, D., Devappa, V., & Yadav, D. K. (2022). Suppression of Tomato Bacterial Wilt Incited by Ralstonia pseudosolanacearum Using Polyketide Antibiotic-Producing Bacillus spp. Isolated from Rhizospheric Soil. Agriculture, 12(12), 2009. https://doi.org/10.3390/agriculture12122009







